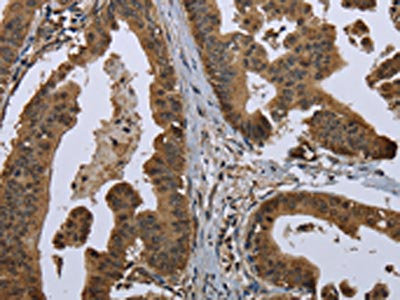

GOLGA2 Antibody
-
中文名稱:GOLGA2兔多克隆抗體
-
貨號:CSB-PA278921
-
規(guī)格:¥1100
-
圖片:
-
The image on the left is immunohistochemistry of paraffin-embedded Human liver cancer tissue using CSB-PA278921(GOLGA2 Antibody) at dilution 1/60, on the right is treated with fusion protein. (Original magnification: ×200)
-
The image on the left is immunohistochemistry of paraffin-embedded Human gastric cancer tissue using CSB-PA278921(GOLGA2 Antibody) at dilution 1/60, on the right is treated with fusion protein. (Original magnification: ×200)
-
Gel: 6%SDS-PAGE, Lysate: 40 μg, Lane 1-4: 293T cells, Hela cells, A172 cells, A549 cells, Primary antibody: CSB-PA278921(GOLGA2 Antibody) at dilution 1/300, Secondary antibody: Goat anti rabbit IgG at 1/8000 dilution, Exposure time: 10 seconds
-
-
其他:
產(chǎn)品詳情
-
Uniprot No.:
-
基因名:
-
別名:130 kDa cis Golgi matrix protein antibody; 130 kDa cis-Golgi matrix protein antibody; Cis golgi matrix protein GM130 antibody; GM130 antibody; Gm130 autoantigen antibody; GOGA2_HUMAN antibody; GOLGA 2 antibody; Golga2 antibody; Golgi autoantigen antibody; Golgi autoantigen golgin subfamily a 2 antibody; Golgi matrix protein GM130 antibody; Golgin 95 antibody; golgin A2 antibody; Golgin subfamily a 2 antibody; Golgin subfamily A member 2 antibody; Golgin-95 antibody; MGC20672 antibody; SY11 protein antibody
-
宿主:Rabbit
-
反應(yīng)種屬:Human
-
免疫原:Fusion protein of Human GOLGA2
-
免疫原種屬:Homo sapiens (Human)
-
標(biāo)記方式:Non-conjugated
-
抗體亞型:IgG
-
純化方式:Antigen affinity purification
-
濃度:It differs from different batches. Please contact us to confirm it.
-
保存緩沖液:-20°C, pH7.4 PBS, 0.05% NaN3, 40% Glycerol
-
產(chǎn)品提供形式:Liquid
-
應(yīng)用范圍:ELISA,WB,IHC
-
推薦稀釋比:
Application Recommended Dilution ELISA 1:2000-1:5000 WB 1:500-1:2000 IHC 1:100-1:300 -
Protocols:
-
儲存條件:Upon receipt, store at -20°C or -80°C. Avoid repeated freeze.
-
貨期:Basically, we can dispatch the products out in 1-3 working days after receiving your orders. Delivery time maybe differs from different purchasing way or location, please kindly consult your local distributors for specific delivery time.
-
用途:For Research Use Only. Not for use in diagnostic or therapeutic procedures.
相關(guān)產(chǎn)品
靶點(diǎn)詳情
-
功能:Peripheral membrane component of the cis-Golgi stack that acts as a membrane skeleton that maintains the structure of the Golgi apparatus, and as a vesicle thether that facilitates vesicle fusion to the Golgi membrane (Probable). Required for normal protein transport from the endoplasmic reticulum to the Golgi apparatus and the cell membrane. Together with p115/USO1 and STX5, involved in vesicle tethering and fusion at the cis-Golgi membrane to maintain the stacked and inter-connected structure of the Golgi apparatus. Plays a central role in mitotic Golgi disassembly: phosphorylation at Ser-37 by CDK1 at the onset of mitosis inhibits the interaction with p115/USO1, preventing tethering of COPI vesicles and thereby inhibiting transport through the Golgi apparatus during mitosis. Also plays a key role in spindle pole assembly and centrosome organization. Promotes the mitotic spindle pole assembly by activating the spindle assembly factor TPX2 to nucleate microtubules around the Golgi and capture them to couple mitotic membranes to the spindle: upon phosphorylation at the onset of mitosis, GOLGA2 interacts with importin-alpha via the nuclear localization signal region, leading to recruit importin-alpha to the Golgi membranes and liberate the spindle assembly factor TPX2 from importin-alpha. TPX2 then activates AURKA kinase and stimulates local microtubule nucleation. Upon filament assembly, nascent microtubules are further captured by GOLGA2, thus linking Golgi membranes to the spindle. Regulates the meiotic spindle pole assembly, probably via the same mechanism. Also regulates the centrosome organization. Also required for the Golgi ribbon formation and glycosylation of membrane and secretory proteins.
-
基因功能參考文獻(xiàn):
- In situ proximity ligation assays of Golgi localization of alpha-mannosidase IA at giantin versus GM130-GRASP65 site, and absence or presence of N-glycans terminated with alpha3-mannose on trans-Golgi glycosyltransferases may be useful for distinguishing indolent from aggressive prostate cancer cells. PMID: 28782625
- GM130 upregulated expression of the key epithelial-mesenchymal transformation regulator Snail (SNAI1), which mediated EMT activation and cell invasion by GM130. PMID: 26617790
- the study identified GM130 as a novel target of Coxsackievirus B3 (CVB3), which may implicate in the pathogenesis of CVB3-induced acute pancreatitis. PMID: 26314804
- We describe the first human patient with a homozygous apparently loss of function mutation in GOLGA2. The phenotype is a neuromuscular disorder characterized by developmental delay, seizures, progressive microcephaly, and muscular dystrophy. PMID: 26742501
- Data show that WAC directly binds to GM130 and that this binding is required for autophagosome formation through interacting with GABARAP regulating its subcellular localization. PMID: 26687599
- Mutagenesis experiments support these structural observations and demonstrate that they are required for GRASP65-GM130 association. PMID: 26363069
- Depletion of GM130 increases cellular velocity and increases the invasiveness of breast cancer cells, therefore supporting the view that alterations of polarity contribute to tumor progression. PMID: 25892554
- GM130 is a parallel homotetramer with a flexible rod-like structure with I- and Y-shaped conformations. PMID: 25787021
- H-ERG trafficking was impaired by H2O2 after 48 h treatment, accompanied by reciprocal changes of expression between miR-17-5p seed miRNAs and several chaperones (Hsp70, Hsc70, CANX, and Golga20) PMID: 24386440
- Induction of autophagy by shGOLGA2 may induce cell death rather than cell survival. Downregulation of GOLGA2/GM130 may be a potential therapeutic option for lung cancer. PMID: 22735382
- GM130 is involved in the control of glycosylation, cell cycle progression, cell polarization and directed cell migration, according to this review. PMID: 20197635
- FXIII-A associated with podosomes & other structures adjacent to the plasma membrane, containing TGN46 & GM130 but not protein disulphide isomerase. FXIII-A was present in GM130-positive intracellular vesicles that could mediate its transport. PMID: 20086247
- the cytoplasmic C terminus of HERG participates in the tethering or possibly targeting of HERG-containing vesicles within the Golgi via its interaction with GM130 PMID: 12270925
- Mammalian Ste20 kinases YSK1 and MST4 target to the Golgi apparatus via the Golgi matrix protein GM130. PMID: 15037601
- Ribbon formation requires the Golgi proteins GM130 and GRASP65. PMID: 16489344
- This is the first report of a role for a Golgi apparatus protein in the regulation of centrosomes during interphase. PMID: 18045989
- depletion of GM130 by RNA interference slows the rate of ER to Golgi trafficking in vivo; interactions of GM130 with syntaxin 5 and Rab1 are regulated by mitotic phosphorylation PMID: 18167358
- Cdc42 has a novel role in controlling centrosome organization in unstimulated cells in addition to its known function as a regulator of centrosome reorientation in stimulated cells. PMID: 19109421
- Data suggest that recruitment of AKAP450 on Golgi membranes through GM130 allows centrosome-associated nucleating activity to extend to the Golgi, to control the assembly of subsets of microtubules. PMID: 19242490
顯示更多
收起更多
-
亞細(xì)胞定位:Golgi apparatus, cis-Golgi network membrane; Peripheral membrane protein; Cytoplasmic side. Endoplasmic reticulum-Golgi intermediate compartment membrane; Peripheral membrane protein; Cytoplasmic side. Cytoplasm, cytoskeleton, spindle pole.
-
蛋白家族:GOLGA2 family
-
數(shù)據(jù)庫鏈接:
Most popular with customers
-
-
YWHAB Recombinant Monoclonal Antibody
Applications: ELISA, WB, IHC, IF, FC
Species Reactivity: Human, Mouse, Rat
-
Phospho-YAP1 (S127) Recombinant Monoclonal Antibody
Applications: ELISA, WB, IHC
Species Reactivity: Human
-
-
-
-
-